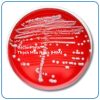
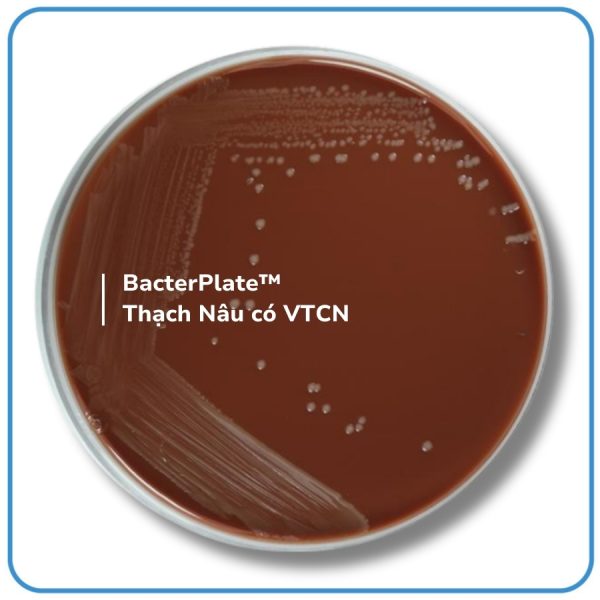
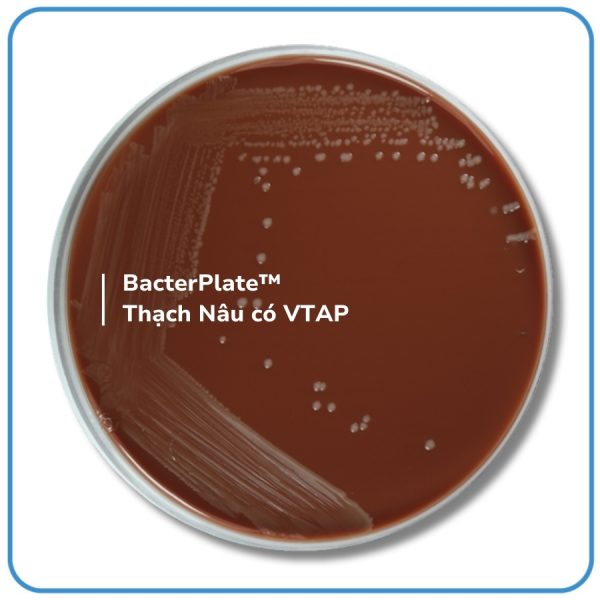
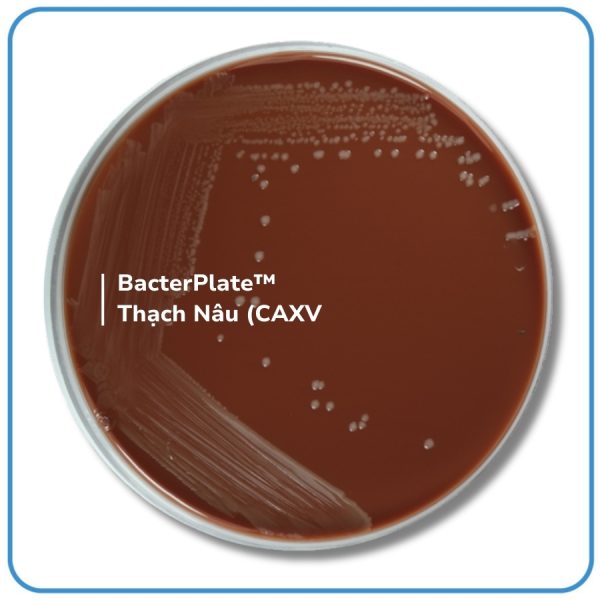

INTENDED USE
- BacterPlate™ Chocolate Agar with VCN (CA VCN) is a selective and enriched medium designed for the cultivation and isolation of Neisseria gonorrhoeae and Neisseria meningitidis from clinical specimens. The VCN supplement inhibits the growth of Gram-positive bacteria, Gram-negative bacteria other than Neisseria, and fungi, making the medium highly specific for fastidious pathogens. This medium is widely used in clinical diagnostics and quality control procedures in microbiology laboratories.
- The typical composition of base medium (Columbia Agar) corresponds to that defined in European (EP), United States (UP) and Japanese (JP) Pharmacopeias.
- The packaging with semi-permeable Cellophane film helps balance the humidity of the environment during storage.
PRINCIPLES
- Peptones included in the composition of the medium favor the excellent growth of colonies.
- Yeast extract is a source of vitamin B complex.
- Starch is a detoxifying agent and also an energy source.
- The heat treatment of blood in the medium lyses red blood cells, releasing growth factors such as hemin (X factor) and NAD (V factor), which are essential for the growth of certain bacteria.
- Vancomycin inhibits the growth of Gram-positive organisms.
- Colistin suppresses most Gram-negative bacteria, excluding Neisseria.
- Nystatin prevents fungal contamination.


 Tiếng Việt
Tiếng Việt